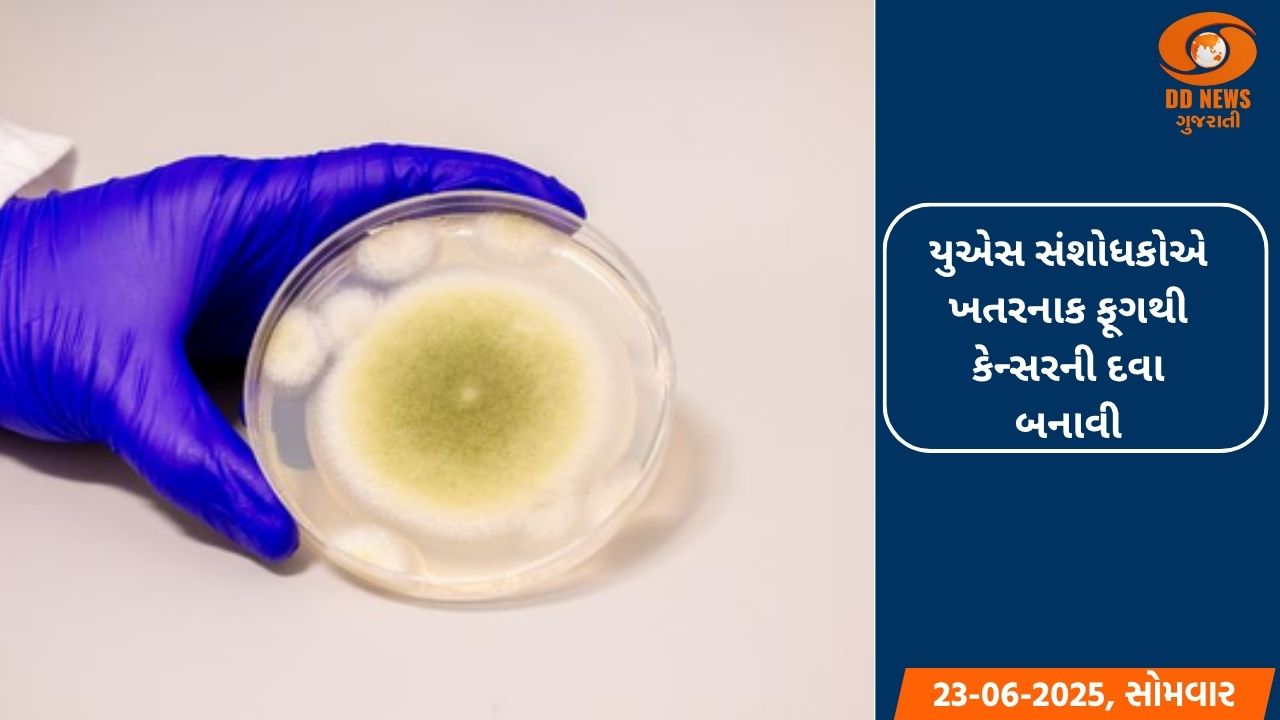
યુએસ સંશોધકોએ ખતરનાક ફૂગથી કેન્સરની દવા બનાવી

ઓપરેશન સિંધુ: ઇઝરાયલથી ભારતીયોની સુરક્ષિત વતન વાપસી
Live TV
-

ઇઝરાયેલથી ભારતીયોનો પહેલો જથ્થો, જેમાં 161 નાગરિકોનો સમાવેશ થાય છે, તેઓ 24 જૂને સવારે 1:19 વાગ્યે દિલ્હી પહોંચ્યા હતા.
ઈરાન-ઇઝરાયેલ સંઘર્ષ વચ્ચે કેન્દ્ર સરકારે પોતાના નાગરિકોની સુરક્ષાને પ્રાથમિકતા આપી છે. ભારત સરકારે પોતાના નાગરિકોની સુરક્ષિત વતન વાપસી માટે 'ઓપરેશન સિંધુ' શરૂ કર્યું છે. આ અભિયાન હેઠળ, ઈરાન અને ઈઝરાયલમાં ફસાયેલા ભારતીયોને સુરક્ષિત રીતે તેમના વતન પરત લાવવામાં આવી રહ્યા છે.
ભારતીય નાગરિકો ઈરાનથી સુરક્ષિત રીતે ભારત પરત ફર્યા
મળતી માહિતી મુજબ, ઓપરેશન સિંધુ હેઠળ મોટી સંખ્યામાં ભારતીય નાગરિકો ઈરાનથી સુરક્ષિત રીતે ભારત પરત ફર્યા છે. તે જ સમયે, ઇઝરાયેલમાં ફસાયેલા ભારતીયોની વાપસી પણ શરૂ થઈ ગઈ છે. આ સંદર્ભમાં, ઇઝરાયલમાં ભારતીય દૂતાવાસે તેની સત્તાવાર સોશિયલ મીડિયા પોસ્ટ દ્વારા માહિતી આપી છે.
અત્યાર સુધીમાં 604 ભારતીય નાગરિકોને ઇઝરાયલથી સુરક્ષિત રીતે બહાર કાઢવામાં આવ્યા
દૂતાવાસનું કહેવું છે કે, અત્યાર સુધીમાં 604 ભારતીય નાગરિકોને ઇઝરાયલથી સુરક્ષિત રીતે બહાર કાઢવામાં આવ્યા છે, જેમને જોર્ડન અને ઇજિપ્ત દ્વારા બહાર કાઢવામાં આવ્યા હતા. ઓપરેશન સિંધુ હેઠળ, ઇઝરાયેલથી ભારતીયોનો પહેલો જથ્થો, જેમાં 161 નાગરિકોનો સમાવેશ થાય છે, તેઓ 24 જૂને સવારે 1:19 વાગ્યે (ભારતીય સમય મુજબ) દિલ્હી પહોંચ્યા હતા.
અત્યાર સુધીમાં બે હજારથી વધુ ભારતીય નાગરિકો ઈરાનથી પોતાના દેશ પરત ફર્યા
ઉલ્લેખનીય છે કે, 'ઓપરેશન સિંધુ' હેઠળ, ભારતીય નાગરિકોના ઘણા ગ્રુપ ઈરાનથી દિલ્હી પહોંચ્યા છે. સોમવારે એક ખાસ ફ્લાઇટ દ્વારા 290 લોકો તેમના દેશ પરત ફર્યા છે. અત્યાર સુધીમાં બે હજારથી વધુ ભારતીય નાગરિકો ઈરાનથી તેમના દેશ પરત ફર્યા છે.
વિદેશ મંત્રાલયના પ્રવક્તા રણધીર જયસ્વાલે શું લખ્યું ?
સોમવારે માહિતી આપતાં, વિદેશ મંત્રાલયના પ્રવક્તા રણધીર જયસ્વાલે સોશિયલ મીડિયા પ્લેટફોર્મ X પર લખ્યું કે, "23 જૂને સાંજે 7.15 વાગ્યે નવી દિલ્હી પહોંચેલા ખાસ વિમાન દ્વારા 290 ભારતીય નાગરિકો અને 1 શ્રીલંકન નાગરિકને મશહદથી બહાર કાઢવામાં આવ્યા હતા. આ સાથે, અત્યાર સુધીમાં 2003 ભારતીય નાગરિકોને ઈરાનથી સુરક્ષિત રીતે પાછા લાવવામાં આવ્યા છે."
ઓપરેશન સિંધુ હેઠળ ભારતના સ્થળાંતર પ્રયાસો ચાલુ
અગાઉ, રવિવારે, રણધીર જયસ્વાલે એક પોસ્ટમાં લખ્યું કે, "ઓપરેશન સિંધુ હેઠળ ભારતના સ્થળાંતરના પ્રયાસો ચાલુ છે. રાજ્યમંત્રી પાબિત્રા માર્ગેરિતાએ 22 જૂનના રોજ 23.30 વાગ્યે નવી દિલ્હી પહોંચતી ખાસ ફ્લાઇટમાં મશહદથી ખાલી કરાયેલા 285 ભારતીય નાગરિકોનું સ્વાગત કર્યું. આ સાથે, અત્યાર સુધીમાં 1,713 ભારતીય નાગરિકોને ઈરાનથી ઘરે લાવવામાં આવ્યા છે."